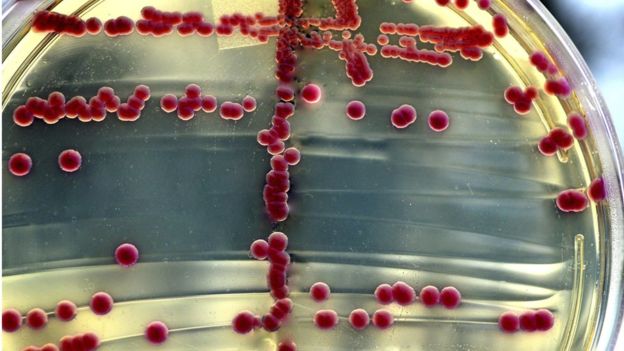

Всем привет, меня зовут Алекс Гусев. Поводом для этой публикации стали интересные и вдумчивые посты коллег @Siberianice, @SergioPrieto и @Kamil_GR — спасибо им за пищу для размышлений. Я задался вопросом: есть ли у нас вообще основания наделять современные большие языковые модели (LLM) субъектностью? Где проходит грань между инструментом и носителем воли? Это не просто изложение моей позиции, а попытка повлиять на восприятие темы. Да, это агитация :-)
Рубрика «мы все умрём»
Не одушевляйте неодушевлённое
2025-07-01 в 10:37, admin, рубрики: а может и нет, мы все умрём, обо всем, ЧитальняСо Stable Diffusion вы можете больше никогда не поверить увиденному в онлайне
2022-09-08 в 15:50, admin, рубрики: dall-e 2, midjourney, stable diffusion, будущее здесь, машинное обучение, мы все умрём, никто не читает теги, обработка изображений, синтез изображений
Примечание переводчика: на Хабре уже есть два перевода про Stable Diffusion, но один описывает частный случай, а другойЧитать полностью »
Влияние кризиса на IT: уволят ли нас всех
2020-06-19 в 9:13, admin, рубрики: Карьера в IT-индустрии, мы все умрём, нас всех съедят, никто не читает теги, рынок труда, финансы в IT
Нередко вижу слова в духе «по другим отраслям коронавирус сильно ударил, а вот IT практически не затронул». Мол, веб-сервисы от карантина только выиграли, писать код можно и удалённо, а раз сейчас ограничения отменяют — значит, всё закончилось хорошо, проблем нет и теперь уже не будет.
По-моему, заявлять такое означает не вполне понимать ситуацию. Существует, например, прогноз Минкомсвязи, что российская IT-отрасль может стать убыточной, а численность российских айтишников во втором полугодии может снизиться на 27 000 человек. Понятия не имею, насколько оправдается конкретно этот прогноз, но поискал разные данные, и в целом они подтверждают: хотя IT и повезло больше многих, картина невесёлая, а уверенно говорить «всё осталось позади» рано.
Как всё могло ухудшиться в период, когда популярность онлайн-сервисов резко возросла? Как происходящее может сказаться на обычном айтишнике? И что ему делать, чтобы сказалось как можно меньше?
Нюансы современной медицины
2020-02-23 в 14:31, admin, рубрики: будущее здесь, все врут, выздоровление или мгновенная смерть, Здоровье гика, мы все умрём, Научно-популярноеСовременная медицина достигла значительных успехов – и сегодня умеет лечить такие болезни, о существовании которых 100 лет назад никто и не подозревал. Однако получить грамотную квалифицированную врачебную помощь по-прежнему непросто – а всё потому, что есть нюансы. О некоторых из этих нюансах и пойдёт речь в этой статье.
 Читать полностью »
Читать полностью »
Возобновляемая энергетика: слова и их значение
2019-01-22 в 6:08, admin, рубрики: возобновляемые источники энергии, глобальное потепление, мы все умрём, углеродный след, экологияСправа на КДПВ вы видите мою машину. При расходе 5 литров солярки на сто километров (на самом деле несколько меньше) и среднем для России пробеге в 16,7 тысяч километров в год она выбрасывает в атмосферу приблизительно 2.2 тонны углекислоты за год (литр солярки образует 2.66 кг углекислоты (.pdf)). Количество зарегистрированных автомобилей на планете превысило миллиард. Сжигание ископаемого топлива личным автотранспортом считается одной из основных причин антропогенной эмиссии CO2.

Слева на КДПВ вы можете видеть мою печку. Весь холодный сезон, с осени до весны я топлю ее дровами. Как говорит нам ВОЗ (.pdf), около трех миллиардов людей на планете пользуются твердым топливом для обогрева или приготовления пищи. За не самый долгий, потому как южный, отопительный сезон я сжигаю порядка пятнадцати кубометров дров, выбрасывая в атмосферу приблизительно 9 — 10 тонн углекислого газа*. Поскольку дрова относятся к возобновляемому биотопливу, отопление ими считается углерод-нейтральным и не вносящим вклада в антропогенную эмиссию CO2.
*Готовых чисел для пересчета дров в углекислоту я не нашел, и в любом случае это гораздо менее точные значения. Впрочем, исходя из массы кубометра дров и массовой доли углерода в древесине, расчет количества углекислоты не представляется особо сложной задачей.
Читать полностью »
Судьба проекта с открытым кодом после смерти программиста
2017-12-04 в 12:57, admin, рубрики: github, open source, мы все умрём, открытый код, передача прав, поддержка, Программирование, разработка проектов
Вы, наверное, никогда не слышали о недавно умершем Джиме Вайрихе [Jim Weirich] или его программах. Но вы почти наверняка пользовались приложениями, построенными на основе его работы.
Вайрих помог создать несколько ключевых инструментов для Ruby, популярного языка программирования, код на котором написан для таких сайтов, как Hulu, Kickstarter, Twitter, и огромного числа других. Исходники его кода были открытыми, что означает, что использовать и изменять их могли все желающие. «Он был плодовитым членом западного сообщества Ruby», — говорит Джастин Сёрлс [Justin Searls], разработчик Ruby и сооснователь компании, разрабатывающей ПО, Test Double.
Когда Вайрих умер в 2014-м, Сёрлс заметил, что уже никто не поддерживает один из инструментов Вайриха для проверки софта. Это означало, что никто не будет одобрять изменения, если другие разработчики пришлют в проект исправления багов, патчи для безопасности или другие улучшения. Любые тесты, основывающиеся на этом инструменте, в итоге будут проваливаться, поскольку код устареет и станет несовместимым с новыми технологиями.
Читать полностью »
В США обнаружен первый случай заражения бактерией, устойчивой к антибиотику «последнего резерва»
2016-05-27 в 22:31, admin, рубрики: антибиотики, будущее здесь, Здоровье гика, кишечная палочка, мы все умрём, Научно-популярное
В четверг официальные представители министерства здравоохранения США сообщили о первом зафиксированном на территории США случае заражения человека новым подвидом кишечной палочки, устойчивой к колистину. Колистин – антибиотик «последнего резерва», использующийся только, когда все остальные лекарства не дали результата. Медики опасаются распространения «супербактерии», как называют устойчивые к антибиотикам микроорганизмы.
«Мы рискуем оказаться в мире, где антибиотики – дело прошлого»,- говорит Томас Фрайден [Thomas Frieden], директор американского центра по предотвращению и контролю заболеваний. Пациент – 49-летняя женщина с инфекцией мочеиспускательного канала. Она не выезжала за пределы страны за последние 5 месяцев, а значит, устойчивый к антибиотикам микроорганизм, скорее всего, появился в США.
Со дня открытия первого антибиотика пенициллина в 1928 году, было открыто не так уж много их различных видов. И каждый раз после открытия нового вида антибиотика в какой-то момент появлялся микроорганизм, выработавший у себя устойчивость к нему благодаря механизмам естественного отбора.
Читать полностью »
Стандартная библиотека Visual Studio 2015 и телеметрия
2016-04-12 в 17:48, admin, рубрики: C, c++, microsoft чёрный властелин, Visual Studio, власти скрывают, и другие пугающие вещи, информационная безопасность, мы все умрём, телеметрия, хитрый план, шапочки из фольги, метки: microsoft чёрный властелин, власти скрывают, и другие пугающие вещи, мы все умрем, телеметрия, хитрый план, шапочки из фольги 
Преамбула
Программы на C и C++, как правило, проводят бо́льшую часть своей жизни внутри функции main() и функций, прямо или косвенно вызываемых из main(). Тем не менее, на самом деле выполнение программы начинается вовсе не с main(), а с некоторого кода из стандартной библиотеки, поставляемой вместе с компилятором. Таковой код, по идее, должен подготавливать окружение для других функций стандартной библиотеки, которые, возможно, позовёт main(), а также параметры самой main() (под Windows; Unix-системы имеют тенденцию передавать argc/argv/envp в подготовленном виде прямо при запуске процесса, но речь не о них). Симметрично, завершающий return в функции main() — вовсе не последняя инструкция программы, после него следует ещё немного кода из стандартной библиотеки.
В Visual Studio «настоящая» точка входа в программу называется mainCRTStartup. В комплекте с VS идут исходники стандартной библиотеки, в VS2015 определение mainCRTStartup находится в %PROGRAMFILES(X86)%VCcrtsrcvcruntimeexe_main.cpp, но, впрочем, всю работу выполняет exe_common.inl рядом. Давайте туда посмотрим.
...
// If this module has any thread-local destructors, register the
// callback function with the Unified CRT to run on exit.
_tls_callback_type const * const tls_dtor_callback = __scrt_get_dyn_tls_dtor_callback();
if (*tls_dtor_callback != nullptr && __scrt_is_nonwritable_in_current_image(tls_dtor_callback))
{
_register_thread_local_exe_atexit_callback(*tls_dtor_callback);
}
__telemetry_main_invoke_trigger(nullptr);
//
// Initialization is complete; invoke main...
//
int const main_result = invoke_main();
//
// main has returned; exit somehow...
//
__telemetry_main_return_trigger(nullptr);
if (!__scrt_is_managed_app())
exit(main_result);
if (!has_cctor)
_cexit();
// Finally, we terminate the CRT:
__scrt_uninitialize_crt(true, false);
return main_result;
...
Бактерии, устойчивые ко всем популярным антибиотикам, добрались до Великобритании
2015-12-23 в 19:53, admin, рубрики: антибиотики, бактерии, мы все умрём, Научно-популярное
21 декабря британские биологи объявили об обнаружении в различных бактериальных пробах, взятых на острове как у людей, так и у домашнего скота, бактерий, содержащих ген mcr-1. Этот ген, появляющийся у микроорганизмов благодаря недавно открытому механизму передачи генов MCR-1, наделяет их способностью сопротивляться колистину – антибиотику, обычно используемому в качестве «последнего средства».
Первый антибиотик, принадлежащий к классу пенициллинов, был открыт в 1928 году, а широкое распространение получил во время Второй Мировой войны. С тех пор было открыто большое разнообразие антибиотиков, разделяемое специалистами на группы, подгруппы и классы. Однако последний класс антибиотиков был открыт в 1987 году – но эволюцию микроорганизмов никто не останавливал.
В рамках естественного отбора после появления нового класса антибиотиков неизбежно появляются бактерии, устойчивые и к этому классу. В связи с этим некоторые исследователи предупреждают об опасности "апокалипсиса антибиотиков" – наступления такого момента, когда против новых штаммов бактерий все известные антибиотики окажутся бессильными. По словам исследователей, после этого человечество вернётся в то не очень приятное прошлое, в котором можно умереть от простого пореза пальца.
Читать полностью »
Бэкдоры в файрволах Juniper
2015-12-18 в 18:31, admin, рубрики: nsa, бекдор, информационная безопасность, мы все умрём, Сетевые технологии, метки: Мы все умрёмЕсли кто-то еще не слышал, Juniper опубликовал заявление: обнаружен код в ScreenOS версий с 6.2.0r15 по 6.2.0r18 и с 6.3.0r12 по 6.3.0r20, позволяющий обладающим соответствующей информацией лицам сделать две вещи:
1) Аутентифицироваться на устройстве по ssh
2) Слушать VPN трафик
Обнаружить проникновение может быть непросто.
Затронута только ScreenOS. SRX в порядке. Наверное.
Подробнее:
forums.juniper.net/t5/Security-Incident-Response/Important-Announcement-about-ScreenOS/ba-p/285554
kb.juniper.net/InfoCenter/index?page=content&id=JSA10713
Есть какие-то Читать полностью »
